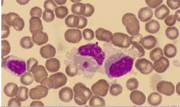

Lista de archivos
Esta página especial muestra todos los archivos subidos.
| Fecha | Nombre | Miniatura | Tamaño | Descripción | Versiones |
|---|---|---|---|---|---|
| 15:05 8 jun 2012 | Anton+Bruckner.jpg (archivo) |  |
22 KB | 1 | |
| 13:59 5 jun 2012 | Bronislaw huberman by olgasha-d390a0s.png (archivo) |  |
263 KB | 1 | |
| 11:00 5 jun 2012 | Early portrait.jpg (archivo) |  |
23 KB | 1 | |
| 13:21 25 may 2012 | Ivry-gitlis.jpg (archivo) |  |
12 KB | 1 | |
| 13:40 21 may 2012 | 468603 tn.jpg (archivo) |  |
21 KB | 1 | |
| 12:32 16 may 2012 | Metastasio.jpg (archivo) |  |
12 KB | 1 | |
| 11:34 10 may 2012 | Genios en el manicomio 2.jpg (archivo) |  |
15 KB | 1 | |
| 11:30 10 may 2012 | Aby warburg.jpg (archivo) |  |
7 KB | 1 | |
| 13:39 9 may 2012 | Andre-chastel-786.jpg (archivo) |  |
10 KB | 1 | |
| 12:38 3 may 2012 | Emilio cordova1 2007.jpg (archivo) |  |
8 KB | 1 | |
| 14:40 7 mar 2012 | Image4987.gif (archivo) | |
19 KB | 1 | |
| 14:01 3 feb 2012 | Chemfig1l99.gif (archivo) |  |
25 KB | 1 | |
| 13:50 20 ene 2012 | Staudingerc.jpg (archivo) |  |
71 KB | 1 | |
| 11:17 6 ene 2012 | San juan.jpg (archivo) |  |
58 KB | 1 | |
| 14:10 16 dic 2011 | S4757 1 wegener granul.GIF (archivo) |  |
20 KB | 1 | |
| 10:33 28 nov 2011 | Ecatepec.gif (archivo) |  |
22 KB | 1 | |
| 11:53 17 nov 2011 | H2o-sirenas-del-mar-150x150.jpg (archivo) |  |
9 KB | 1 | |
| 11:39 17 nov 2011 | Claire Holt 2.jpg (archivo) |  |
13 KB | 1 | |
| 12:32 27 oct 2011 | Bouchard.jpg (archivo) |  |
10 KB | 1 | |
| 12:22 27 oct 2011 | Bouchardat1.jpg (archivo) |  |
30 KB | 1 | |
| 12:20 27 oct 2011 | Bouchardat2.jpg (archivo) |  |
36 KB | 1 | |
| 14:24 26 oct 2011 | Gilbert-01-cp.jpg (archivo) |  |
12 KB | 1 | |
| 14:48 20 oct 2011 | Italo-gotico alcaniz.jpg (archivo) |  |
47 KB | 1 | |
| 14:40 20 oct 2011 | Arte-gotico-pintura.jpg (archivo) |  |
12 KB | 1 | |
| 13:33 1 oct 2011 | Alfred Kubin 1904.jpg (archivo) |  |
17 KB | 1 | |
| 15:16 22 sep 2011 | Otis-Redding---(Sitting-On)-The-Dock-of-the-Bay-.jpg (archivo) |  |
33 KB | 1 | |
| 12:35 8 sep 2011 | Augustodipaolo.jpg (archivo) |  |
86 KB | 1 | |
| 10:56 27 jul 2011 | Disco.jpg (archivo) |  |
10 KB | 1 | |
| 11:43 22 jul 2011 | Les revenants paul feval.jpg (archivo) |  |
12 KB | 1 | |
| 11:42 22 jul 2011 | Paul feval novelas relatos hija del castigo.jpg (archivo) |  |
11 KB | 1 | |
| 11:26 22 jul 2011 | Caballero tenebroso paul feval.jpg (archivo) |  |
11 KB | 1 | |
| 11:13 22 jul 2011 | Paul feval.jpg (archivo) |  |
12 KB | 1 | |
| 08:47 24 jun 2011 | 220px-JoyceUlysses2.jpg (archivo) |  |
12 KB | 1 | |
| 12:31 20 jun 2011 | Dmloynazjardin.jpg (archivo) |  |
9 KB | 1 | |
| 11:26 17 jun 2011 | Simplegas.jpg (archivo) |  |
9 KB | 1 | |
| 11:23 17 jun 2011 | Jason y el vellocino.jpg (archivo) |  |
77 KB | 1 | |
| 11:20 17 jun 2011 | Vellocino-de-oro-031.jpg (archivo) |  |
41 KB | 1 | |
| 10:11 1 jun 2011 | Charles-edouard-guillaume3.jpg (archivo) |  |
40 KB | 1 | |
| 15:47 30 may 2011 | Anubis 4.jpg (archivo) |  |
52 KB | 1 | |
| 15:46 30 may 2011 | Anubis007.jpg (archivo) |  |
27 KB | 1 | |
| 15:42 30 may 2011 | Anubis.png (archivo) |  |
43 KB | 1 | |
| 09:11 26 may 2011 | 03.jpg (archivo) |  |
9 KB | 1 | |
| 13:21 18 may 2011 | Pegaso1.jpg (archivo) |  |
29 KB | 1 | |
| 13:01 17 may 2011 | PERRO2.jpg (archivo) |  |
17 KB | 1 | |
| 16:18 16 may 2011 | Capsicum-frutescens-chile-c.jpg (archivo) |  |
7 KB | 1 | |
| 14:16 16 may 2011 | Museo-nuevo-egipto.jpg (archivo) |  |
29 KB | 1 | |
| 14:09 16 may 2011 | Museo-nuevo-sala.jpg (archivo) |  |
28 KB | 1 | |
| 14:08 16 may 2011 | Museo berlin.jpg (archivo) |  |
48 KB | 1 | |
| 10:36 11 may 2011 | Virescens 01.jpg (archivo) |  |
28 KB | 1 | |
| 09:14 11 may 2011 | Blue mountain state ver2 xlg.jpg (archivo) |  |
326 KB | 1 |